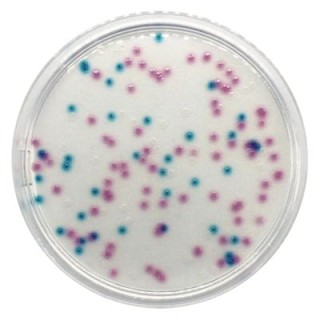
Chromogenic Coliform Agar gotowa pożywka do oznaczania Escherichia coli
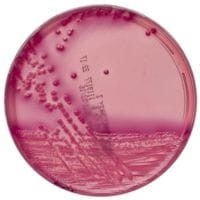
MacConkey Agar No. 3 gotowa pożywka do wykrywania E. coli

Transwab - wymazówka plastikowa z podłożem Amies, z węglem drzewnym
• Opakowanie: 125 szt
• Podłoże Transportowe: Amies Agar Gel z węglem
• Długość: 150mm
• Wyrób medyczny: Tak
Cena
zawiera 8% VAT, bez kosztów dostawy
Cena netto
184,64 zł
bez 8% VAT i kosztów dostawy
Dostępność
Na magazynie (czas dostawy 3-5 dni)
Wysyłka
Zgodnie z informacją o stanie magazynowym
Termin dostawy jest szacowany na podstawie dostępności produktu u poroducenta, termin dostawy dla towaru dostępnego wynosi 3 do 5 dni roboczych od daty zaksięgowania wpłaty, w przypadku dodatkowych pytań skontaktuj się poprzez czat z naszym specjalistą
Dostawa
Koszt dostawy uzależniony od wartości zamówienia, dla zamowień powyżej 800,00 netto wynosi 0 zł, standardowy koszt dostawy 35,00 zł netto
Producent
MW&E
 Opis
Opis
 Koszty dostawy
Cena netto, nie zawiera podatku
Koszty dostawy
Cena netto, nie zawiera podatku
Kraj wysyłki:
darmowa i wygodna wysyłka
już od 800 zł netto
Najwyższa jakość
produktów potwierdzona certyfikatami
Zakupy 24h na dobę
wygodne i bezpieczne
bezpłatna konsultacja
z ekspertem online